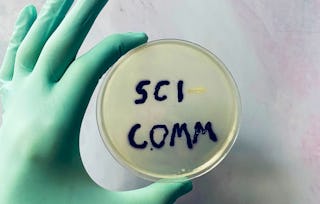

This course will prepare you for teaching science in higher education. In this MOOC you will learn to make your knowledge as an excellent researcher accessible to your students. We will show you how to communicate science to novices as well as advanced students in science. You will experience the value of teaching with analogies and you will be guided to train your students' competences. Based on up-to-date findings from research into teaching and learning science you will be able to

Teaching Science at University

Teaching Science at University


Instructors: Kai Niebert
Access provided by Inter IKEA
12,607 already enrolled
196 reviews
Details to know

Add to your LinkedIn profile
See how employees at top companies are mastering in-demand skills

There are 5 modules in this course
Instructors


Offered by
Why people choose Coursera for their career

Felipe M.

Jennifer J.

Larry W.

Chaitanya A.
Learner reviews
- 5 stars
74.11%
- 4 stars
18.78%
- 3 stars
4.06%
- 2 stars
0.50%
- 1 star
2.53%
Showing 3 of 196
Reviewed on Mar 2, 2018
This is a very exceptional course for me as a teacher. Very helpful insights and learnings. Thanks Prof. Dr. Kai Niebert for you wonderful teaching methodologies. God bless you.
Reviewed on Nov 5, 2023
This course is very very information and it help me that in what ways I will convey science concepts to the students. Great experience. Thanks
Reviewed on Jul 23, 2021
The course was resourcefull and inspiring with relevant material and good planning structure
Explore more from Personal Development

University of Amsterdam
University of Colorado Boulder

The University of Hong Kong

Institut Mines-Télécom
¹ Some assignments in this course are AI-graded. For these assignments, your data will be used in accordance with Coursera's Privacy Notice.

